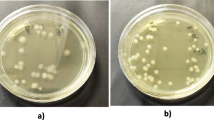

Abstract
Liquid microbial inoculants have recently received great attention due to their vital roles for sustainable agricultural practices. However, long-term conservation under ambient temperature conditions and deleterious environmental factors might negatively impact microbial cell survival and limit their efficacy in the field. Thus, developing efficient liquid formulation providing prolonged survival of rhizobia in the final product and after an application is crucial. Therefore, this study investigates the effect of various additives on the long-term survival of rhizobia stored in liquid cultures at room temperature (25 °C) for 12 months. Various yeast sucrose media amended with polyvinylpyrrolidone (PVP) or gum arabic as colloidal agents in combination with ectoine (as a compatible solute) and/or glycerol were evaluated. A dramatic decline in viable cell count was obtained in formulas amended only with PVP from Log 8.5 to Log 5 in the first six months and then to Log 1.5 after 12 months. In contrast, rhizobia stored at PVP-based formulas amended with 10 mg L‒1 ectoine exhibited almost constant survival level till the end of the storage period. The same trend was obtained using formulas based on gum arabic as a colloidal dispersing agent; however, less decline in cell count using a formula containing gum arabic alone as compared to using PVP. On the other hand, PVP based formulas exhibited higher viscosity compared with another formula. Increased viscosity till the 8th month of storage was achieved in the presence of ectoine indicating the increase of exopolymeric substances production. Electrophoretic protein pattern of rhizobial cells (stored for 12 months) exhibited several low molecular weight protein bands in cells stored in PVP based formula with ectoine as compared to the other treatments. Thus, the amendment of the liquid formulation of rhizobia bioinoculant with PVP plus ectoine not only improved cell survival but also enhanced the culture viscosity and consequently ameliorate the colonization and performance of rhizobial inoculants.
Graphic Abstract

Similar content being viewed by others
Explore related subjects
Discover the latest articles, news and stories from top researchers in related subjects.Avoid common mistakes on your manuscript.
Introduction
Microbial inoculant formulation is a promising technology that has been designed to safely improve the productivity of economic crops in the long-run application. It was previously reported that the major part of bio-fertilizers is produced in the form of carrier-based inoculants. However, solid carrier-based technology is considered as an energy-consuming process and involving milling, as well as sieving of the solid carrier in addition to pH adjustment are required [1, 2]. On the other hand, liquid bio-inoculant formulation has become the ideal substitution of carrier-based inoculants for many reasons [3]. For example, in liquid bio-inoculants, rhizobia broth cultures are supplemented with substances that maintain cell viability during storage and after application for seeds or soil. These additives protect rhizobial cells from drastic conditions such as high temperature and desiccation. The microbial cells of liquid bio-inoculant can tolerate high temperatures up to 55 °C [4]. The average shelf-life of most solid carrier-based bio-fertilizers is about 180 days; however, the shelf-life period could be increased up to two years when the liquid formulation is used.
Liquid inoculant formulations have been observed to serve as effective inoculants for rhizobia. Liquid formulations are typically aqueous, oil, or polymer-based products that are generally consisted of certain compounds serving as cell protectants in addition to specific nutrient media components used for the growth of plant growth-promoting rhizobacteria (PGPR) [5]. Polysaccharides such as gums, carboxymethylcellulose, and polyalcohol derivatives are commonly used to alter the fluid properties of these formulations [6]. Liquid formulations offer several advantages including stabilization of the microorganisms during production, packaging, distribution, and storage, and ease mixing with the seeds. Other applicable features are the protection of microbes from unfavorable environmental field conditions and enhancement of microbial activity at the site of application through increasing its viability, generation, adherence, and interaction with the target crops [7].
Ectoines (1,4,5,6-Tetrahydro-2-methyl-4-pyrimidinecarboxylic acid) are low-molecular weight compounds produced by a wide range of halophilic microbial species. They are highly soluble in water (about 4 M at 20 °C) and can act as a compatible solute [8,9,10]. Ectoines have been classified as an excellent universal osmoprotectant [11,12,13]. Ectoine and hydroxyl ectoine are also reported to protect living cells against abiotic stress factors such as heating, desiccation, and freezing [14,15,16]. These criteria introduce the appropriate application of ectoine in different fields related to agriculture, molecular biology, food industries, biotechnology, and pharmacy [17]. Louis et al. investigated the protective function of hydroxyectoine and ectoine on Escherichia coli K12 and E. coli NISSLE 1917 during drying and subsequent storage. They found that those tetrahydropyrimidines molecules could introduce protection to freeze-dried E. coli NISSLE 1917 [18].
Besides, several compounds have been also studied for their potential as cell protectors during rhizobia production and storage. For example, polyvinylpyrrolidone (PVP) has been used as a polymer that protects the microbial cell from toxic seed defeated releasing from seed coat during germination. Moreover, it has high water binding capacity which alleviates the drying of the inoculant at the field. Fe-EDTA and glycerol had been also added to the liquid formula of rhizobia as iron and carbon source, respectively. Glycerol can also protect cells from the effects of desiccation [19]. Moreover, polysaccharides such as gum arabic, carboxymethyl cellulose (CMC), and polyalcohol derivatives are widely used to adjust the fluid properties of liquid formulations [6]. Tittabutr et al. studied the potential of bradyrhizobial liquid formulations amended with gum arabic, sodium alginate, polyethylene glycol (PEG), polyvinyl pyrrolidone (PVP), polyvinyl alcohol (PVA), and cassava starch compared with peat-based inoculant under field conditions and they concluded that liquid inoculants based on sodium alginate enhanced long-term survival of tested rhizobial strains in culture media while peat provided the highest protection to microbial cells after application to the seeds and incubation at 40 °C. Gum arabic based formulas maintained the bradyrhizobia number at 105 cells/seed after 48 h of incubation. Also, liquid inoculant amended with sodium alginate, PVP, or cassava starch supported survival at only 104–105 cells/seed [20].
The unavailability of suitable formula in which bacteria are allowed to multiply and survive for long period due to the short shelf-life of bio-fertilizers is a major constraint. Therefore, developing effective liquid rhizobial inoculants with enhanced long-term survival and storage stability is a critical challenge. Consequently, this study aimed to assess the effect of PVP or gum arabic in combination with ectoine and/or glycerol on the survival of rhizobia in liquid formulation along 12 months of storage.
Material and Methods
Bacterial Strain and Growth Conditions
Rhizobium sp. SARS 81 was provided from Bacteriology Laboratory, Sakha Agricultural Research Station, Kafr El-Sheikh, Egypt. Pure cultures were routinely maintained on Yeast Extract Mannitol Agar (YEMA) medium.
Ectoine Source
Ectoine was extracted from 48 h old culture of Chromohalobacter salexigens strain TA1 growing in Sehgal and Gibbons complex broth medium (SGCb medium) [21]. Briefly, cell pellets of C. salexigens were collected by centrifugation at 5000 rpm undercooling and were washed by phosphate buffer (pH 7.0) supplemented with NaCl (200 g L‒1). Washed cells were resuspended overnight in 80% (v/v) ethanol then centrifuged at 5000 rpm undercooling. The supernatant was used as a source of ectoine. The concentration and purity of ectoine in the supernatant was determined by HPLC with a TSK-GEL reversed-phase column (Tosoh, Japan) as described by Zhang et al. [22]. Ethanolic solution of ectoine was concentrated in rotary-evaporator at 60 °C and the resulted ectoine were dissolved in distilled water to obtain 1000 mg L‒1 concentration (stock solution), filtered through 0.22 µ syringe filter and amended to the Yeast- Sucrose Media as a solution.
Experimental Design
Eleven formulations were prepared as shown in Table 1 to investigate the performance of compatible solutes (ectoine and/or glycerole) in combination with dispersant agents (PVP or gum arabic) for improvement of rhizobia survival in liquid inoculants and its effect on nodulation efficiency at the end of 12 months storage.
Shelf Life of Liquid Inoculant and Storage Condition
Cells were grown in 500 mL Erlenmeyer flasks containing 200 mL of yeast sucrose medium and adjusted at pH 6.8 with the appropriate concentrations of additives before sterilization as described earlier. The flasks were incubated at 30 °C for 48 h on a rotary shaker at 150 rpm. Aliquots of 50 mL of culture were distributed into 100 mL capacity sterile screw-capped glass bottles. These bottles were stored at room temperature and the total viable count, culture pH, and culture viscosity were determined every month. Data of viable count obtained by plate count were expressed as Log CFU mL‒1.
Viscosity Estimation
The rhizobial culture was centrifuged at 5000 rpm for 20 min, and the viscosity was measured in the supernatant using U shaped Ostwald viscometer using distilled water as a reference liquid according to the following equation:
where ρs is the density of a sample, ts is the time of outflow of the sample, ρw is the density of water, tw is the time of the outflow of water ηw is the viscosity of water. The resulting data were expressed in centipoise unit.
Quantification of Exopolymeric Substances (EPS).
Cells were harvested by centrifugation at 5000 rpm for 20 min, and the supernatant was treated with two volumes of cold ethanol, held overnight at − 18 °C, and then centrifuged undercooling (4 °C) at 10,000 rpm for 20 min using BECKMN J2-MC centrifuge. The polysaccharide pellets were dissolved in warm distilled water, dialyzed against distilled water for several runs, lyophilized, and then weighted. The obtained product were analyzed for total carbohydrate and protein content [23].
Total Carbohydrates Determination
One mL of 5% phenol solution was added to 0.1 mL of 1% EPS solution. Then, 5 mL of concentrated H2SO4 was added rapidly to the mixture, shaked, and left aside for 30 min at room temperature. The color density was measured at 490 nm wavelength using JENWY 6705 spectrophotometer. Glucose was used as a standard solution [24].
Protein Patterns
Rhizobia cells of each treatment were harvested by centrifugation at 5000 rpm for 15 min at 4 °C, washed by 50 mmol L‒1 Tris–HCl (pH 7.5) and resuspended in 200 µL of the same buffer. The cells were sonicated for 5 min at 15 s intervals at 4.0 °C using a sonicator Vibra-Cell 100 W model (Sonic & Materials Inc., Danbury, CT, USA). Lysates were centrifuged at 10,000 rpm for 20 min at 4 °C to remove cell debris. Protein electrophoresis was carried out in 15% SDS–polyacrylamide gels [25]. Gels were fixed and stained with Coomassie-Brilliant Blue as described by Arndt et al. [26].
Pot Experiment
Seeds of cowpea (Vigna unguiculata L. Walp.) obtained kindly from Legumes Research Department, Field Crops Research Institute, Agriculture Research Center, Egypt were surface sterilized by soaking in 2.5% sodium hypochlorite for 3 min and then washed 5 times in sterile distilled water and then mixed with liquid inoculant at a rate of 10 mL inoculant for 100 seeds before sowing in pots of 5 kg capacity filled with sterilized clay soil collected from experimental farm of Sakha Agriculture Research Station (SARS) at a depth of 0‒20 cm with the following composition pH 8.10, organic matter (OM) 1.54%, total nitrogen 479 mg kg‒1, available phosphorous 11 mg kg‒1, available potassium 365 mg kg‒1, available Zn 0.75 mg kg‒1, available Fe 5.35 mg kg‒1 and available Mn 2.85 mg kg‒1. The experiment was conducted in triplicats and each pot received two sterilized cowpea seeds inoculated according each treatment. At 60 days from planting, the plant was pulled gently and roots were cleaned and washed with running tap water then the nodule number, nodules dry weight and plant dry weight were determined.
Statistical Analysis
Data were statistically analyzed using Co Stat-statistical package software version 6.303. One-way analysis of variance (ANOVA) was used to compare the treatments. Multiple comparisons were done using Tukey's range tests at P < 0.05. All results are the means of three independent replicates as specified above.
Results and Discussion
Survival of Rhizobia in Different Liquid Formulations
Different liquid formualations were prepared for the rhizobial growth and storage as shown in Table 1. Rhizobia showed well growth and multiplication in yeast sucrose media at all treatments during the incubation period at room temperature with an average viable count reached about log 9 CFU mL‒1 (Table 2). In general, the average viable count was increased in all treatments reaching about Log 10.2 CFU mL‒1 after storage for two months. Almost all formulas had conserved viable cells until the fifth month of storage where some treatments started to decline after that. A sharp decline in the viable count was obtained in the treatment T2 (YSM + PVP) and T3 (YSM + PVP + Gly) that reached down to Log 1.8 and Log 1.54, respectively (Table 2). Therefore, the presence of glycerol only as a compatible solute and osmoprotectant did not prevent/recover the decline in viable count in the presence of PVP. While the treatments amended with ectoine were able to survive for a longer time than other treatment even in the presence of PVP or gum arabic as dispersant agents where the best treatment was T4 (PVP + Ectoine) which recorded viable Log count 9.93 at the end of the storage period.
Sucrose was used as a carbon source due to its protective properties. It was reported to enhance the survival of certain Rhizobium spp [27,28,29], and stimulate the accumulation of compatible solute glycine betaine (betaine) inside the cell [30]. Sucrose is also used by bacterial cells for the synthesis of glycocalyx which play a significant role in the survival of various microorganisms [31, 32]. Polyvinylpyrrolidone (PVP) and gum arabic were used to maintain the bacterial growth suspended in the growth medium along the storage period through what is called colloidal stabilization that prevents protein precipitation or cell coagulation [5].
At the current work, the reduction in cell count of rhizobia was recorded in treatments containing 2% PVP alone or with glycerol after 5 months of storing. This may be attributed to the that PVP has high phenolic content and high binding activity to polar and hydrophobic molecules [33], which may affect the plasma membrane of the microbial cell especially when exposed for a prolonged time. This sharp decline in the viable count at treatments 2, 3 might also be attributed to the consumption of sucrose in the 5th month. So, the medium became free from not only carbon source but also compatible solute (sucrose) which preserves the cell from injury under osmotic pressure caused by PVP. Our results are in agreement with previous research which showed that compounds with high-molecular-weight (C6 to C12) such as sucrose can improve the survival of bacteria in dried biopolymers [29] or enhance the survival of Rhizobium spp. upon desiccation and/or dry formulation [27, 28].
On the other hand, ectoine could retrieve the survival of cells for a longer storage periods. The viable count in formulas containing ectoine remain constant until the 9th month of storage then a gradual decrease was observed after that except in the case of T4 (YSM + PVP + Ectoine) whereas the cell viable count remains constant until the end of the storage period.
Compatible solutes as betaine had been long used as additives in liquid formulations of PGPRs. Among several products, ectoine showed a promising ideal compatible solute in preserving the viability of liquid rhizobial culture at the current study. Ectoine can protect and stabilize proteins, nucleic acids, and whole cells against those stresses where they can collapse and proteins tend to be denatured especially in the worm environment. Zhang et al. proposed that ectoine improved cell division and assimilation of glucose, and protected the relative enzymes during ethanol production by Zymomonas mobilis [34]. Talibart et al. investigated the role of ectoine in the osmo-adaptation of Rhizobium meliloti and they found that ectoine improved the growth of R. meliloti under adverse osmotic conditions (0.5 M NaCI) without being accumulated by the cells. It was suggested that the mechanism of action is situated at the gene expression level [13]. This finding explains the difference in protein profiles between the treatments as shown in Fig. 1. Ectoine also proved to osmoprotectant several species of rhizobia such as Rhizobium leguminosarum, Bradyrhizobium japonicum, and Rhizobium sp. [13].
SDS-PAGE of total soluble protein of Rhizobium sp. (vigna) tal169 stored for 12 months at room temperature. Lane M: molecular mass standards (kit Mw- GF-1000- Sigma). Lane T2, Culture media amended with 2% PVP; lane T3, Culture media amended with 2% PVP + 0.5% glycerol; lane T4, Culture media amended with 2% PVP + 1.0% Ectoine [10 mg L‒1]; Lane T5, Culture media amended with 2% PVP + 0.5% glycerol + 1.0% Ectoine [10 mg L‒1]; lane T1 (control). The numbers beside arrows indicate the changes observed as explained in the text
Changes in pH and Viscosity (Centipoise Unit) of Culture Media
Results shown in Table 3 indicated that, although there are statistical differences between the treatments during the storage period of liquid inoculants in the pH values, however, this change cannot be attributed to the effect of any of the additives used in the experiment. All treatments showed a significant decrease in pH values at the end of the storage period compared to the pH measured at the initial time.
On the other hand, there are great variations in viscosity between different treatments (Table 4). As expected, the formulas containing colloidal agents possess the highest viscosity rate but it continued to increase during the continuos storage period. The increase in rheological properties with the time indicates that the viscosity resulted from the production of exopolymeric substances (EPS). This suggestion is confirmed by the estimation of polysaccharide in all formulations under study. The increase in viscosity was not proportional to the increase in the viable count where the viscosity continued to increase although the bacterial count was constant. The highest increase in viscosity was achieved in treatments containing ectoine that reached ˃300 centipoise units in treatment T4 and up to 140 centipoise unit in treatments T5, T8, and T9. On the other hand, the increase in viscosity was stopped when the viable cell count started to decline (Table 4). Formulations containing glycerol showed lower viscosity compared with the analogous treatment without glycerol (Table 4). Glycerol based media are used as a carbon source by many rhizobial strains. Lorda and Balatti studied the growth behavior of B. japonicum in glycerol-based media under various environmental conditions. They showed a rapid growth rate in a medium supplemented with glycerol instead of mannitol. The current work suggested that the rhizobial strain at glycerol- amended medium used glycerol as a protective agent. Glycerol possesses high water binding capacity which protects rhizobial cells from desiccation during application to the seeds [35].
Quantification of Exopolymeric Substances (EPS)
The varied viscosities among treatments were attributed to differences in polysaccharide production. The quantification of exopolymeric substances and carbohydrate content of culture media after 12 months was shown in Table 5. This could be a fruitful area of the investigation if the effect of PVP and polysaccharides on cell survival is synergistic. Polysaccharide plays several roles in rhizobia survival as it protects rhizobial cells from desiccation, metallic cations, and/or stress-induced by acid soil.
Treatments with high viscosity gave a higher value for EPS that reached to 6.8 g L‒1 at treatment 9 containing ectoine. The carbohydrate content was higher than 80% in all treatments. Although PVP containing formulas possess a higher viscosity compared to other formulas containing gum arabic; however, the EPS content in the last was higher due to the chemical nature of gum arabic which is composed mainly of carbohydrate (Treatments T7, T8, and T9).
Nodule Formation of Rhizobia Stored in Different Formulations
Generally, the viscosity and the ability of liquid inoculant to easily adhesion to plant parts is a preferable and limiting character for microbial liquid formulation. It helps microorganisms to colonizes the target surfaces and increase the bacterial population on the seeds. In the current study, the high viscosity of treatments especially those containing ectoine would be advantageous that can play an effective role in the nodulation process.
At the end of the storage period, the nodulation efficiency of stored cultures was examined to evaluate the viability of rhizobia and its validity to form nodules. In this experiment, only equal volumes of stored cultures were added to equal quantity of seeds to investigate the actual activity of stored inoculates, thus, the number of viable cells was not equal between stored treatments. It was clear that the application of treatments with high rhizobial number achieved the highest nodulation nodule formation as shown in Table 6. This was reflected on plant growth parameters as plant dry weight and nitrogen content were increased. Formulation containing ectoine and PVP (T4 and T5) showed the highest nodule number (23, 17 nodule −1), with plant dry weight (3.64 and 3.45 g) and N-content (1.61, 1.32%), respectively. The application of other treatments exhibited lower values as indicated in Table 6.
Liquid inoculant formulation of cowpea rhizobia prepared with PVP as an osmoprotectant had been observed to have higher shelf life than those without the PVP amendment [36]. In contrast, some researchers reported a negative effect on cell viable count by the addition of PVP. Dayamani and Brahmaprakash reported that the viable count of Azospirellium was decreased with PVP at a 0.5% level [7].
Electrophoretic Protein Pattern
The electrophoretic protein patterns of cells stored for 12 months in liquid formulations containing PVP are shown in Fig. 1. As indicated, formulations amended with ectoine affected the synthesis of cell proteins. Comparative analysis of the lanes showed that the protein bands are similar in case of treatment amended with glycerol and control (lane 2, 5). Also, these bands were common in all PVP treatments. Two low molecular weight protein bands (31 and 12 kDa) appeared in the treatment containing PVP alone (lane 1) which were not produced under control condition. Furthermore, two protein bands of molecular weights 68, and 56 kDa were appeared at the treatment containing ectoine in its formulation.
Fetyan and Mansour previously reported that a halotolerant strain R. meliloti-n11 showed two new protein bands (48 and 32 kDa) under salt stress that were not produced under normal condition. Also, they found protein bands of molecular weights 108, 68, and 53 kda were intensified under stress conditions [37]. The presence of ectoine regulates the genes responsible for the alleviation of osmotic stress.[13]. Further studies to characterize the chaperons produced under different stress conditions pending necessary to give more clear mechanism of the inoculant additives.
Conclusion
In this study, various liquid formulations containing PVP or gum arabic in combination with ectoine and/or glycerol were evaluated for rhizobia (Rhizobium sp. SARS 81) growth and storage. The liquid formulation containing ectoine plus PVP was considered the best for developing efficient rhizobial liquid bio-inoculants with enhanced long-term survival and storage stability. Amongst all additives, ectoine at 10 mg L‒1 exhibited the best performance of microbial cells during the prolonged storage of up to 12 months at room temperature. It improved rhizobial survival under storage and enhanced production of exopolymeric substances that lead to increased viscosity and consequently potential for better application as a stronger adhesive to the plant surfaces and colonization performance. Besides this, formulations containing ectoine showed better nodules formation with Vigna unguiculata. Also, some stress protein bands with molecular weights 68, and 56 kDa appeared in the cells stored in the formulations containing ectoine. Further efforts should be done to determine the possible mechanism of ectoine and the maximum preservation period.
Data Availability
The datasets used and/or analyzed during the current study are available from the corresponding authors on reasonable request.
References
FAO (1991) Report of expert consultation on legume inoculantproduction and quality control. FAO, Rome, p 148
Somasegaran P, Hoben JH (1994) Hand book for rhizobia, methods in legume-rhizobium technology. Springer, NewYork . https://doi.org/10.1007/978-1-4613-8375-8
Kumaresan G, Reetha D (2011) Survival of Azospirillum brasilense in liquid formulation amended with different chemical additives. J Phytol 3(10):48–51
Mahdi SS, Hassan GI, Samoon SA, Rather HA, Dar SA, Zehra B (2010) Biofertilizers in organic agriculture. J Phytol 2:42–54
Deaker R, Roughley RJ, Kennedy IR (2004) Legume seedinoculation technology—a review. Soil Biol Biochem 36:1275–1288. https://doi.org/10.1016/j.soilbio.2004.04.009
Paau AS (1989) Formulations usiful in applying beneficial microorganisms to seeds. Trends Biotechnol 6:276–279
Dayamani KJ, Brahmaprakash GP (2014) Influence of form and concentration of the osmolytes in liquid inoculants formulations of plant growth promoting bacteria. Int J Sci Res Publ 4:7
Zaccai G, Bagyan I, Combet J, Cuello GJ, Deme B, Fichou Y, Gallat FX, Galvan Josa VM, Von Gronau S, Haertlein M et al (2016) Neutrons describe ectoine effects on water H-bonding and hydration around a soluble protein and a cell membrane. Sci Rep 6:31434
Pastor JM, Salvador M, Argandona M, Bernal V, Reina-bueno M, Csonka BLN, Iborra JL, Vargas C, Nieto JJ, Canovas M (2010) Ectoines in cell stress protection: uses and biotechnological production. Biotechnol Adv 28:782–801. https://doi.org/10.1016/j.biotechadv.2010.06.005
Kunte HJ, Lentzen G, Galinski E (2014) Industrial production of the cell protectant ectoine: protection, mechanisms, processes, and products. Curr Biotechnol 3:10–25. https://doi.org/10.2174/22115501113026660037
Gouesbet G, Trautwetter A, Bonnassie S, Wu LF, Blanco C (1996) Characterization of the Erwinia chrysanthemi osmoprotectant transporter geneous A. J Bacteriol 178:447–455. https://doi.org/10.1128/jb.178.2.447-455
Jebbar M, Talibart R, Gloux K, Bernard T, Blanco C (1992) Osmoprotection of Escherichia coli by ectoine: uptake and accumulation characteristics. J Bacteriol 174:5027–5035. https://doi.org/10.1128/jb.174.15.5027-5035
Talibart R, Jebbar M, Gouesbet G, Himdi-kabbab S, Wroblewski H, Blanco C, Bernard T (1993) Osmoadaptation in Rhizobia: ectoine-induced salt tolerance. J Bacteriol 176(17):5210–5217
Kuhlmann AU, Bursy J, Gimpel S, Hoffmann T, Bremer E (2008) Synthesis of the compatible solute ectoine in Virgibacillus pantothenticus is triggered by high salinity and low growth temperature. Appl Environ Microbiol 74:4560–4563. https://doi.org/10.1128/AEM.00492-08
Roberts MF (2005) Organic compatible solutes of halotolerant and halophilic microorganism. Saline Syst 1(5):1746–1448. https://doi.org/10.1186/1746-1448-1-5
Vargas C, Argandona M, Reina-bueno M, Rodríguez-moya J, Fernández-aunión C, Nieto JJ (2008) Unravelling the adaptation responses to osmotic and temperature stress in Chromohalobacter salexigens, a bacterium with broad salinity tolerance. Saline Syst 4(1):14. https://doi.org/10.1186/1746-1448-4-14
Van-thuoc D, Guzmán H, Quillaguamán J, Hatti-kaul R (2010) High productivity of ectoines by Halomonas boliviensis using a combined two-step fed-batch culture and milking process. J Biotechnol 147(46):51. https://doi.org/10.1016/j.jbiotec.2010.03.003
Louis P, Trüper HG, Galinski EA (1994) Survival of Escherichia coli during drying and storage in the presence of compatible solutes. Appl Microbiol Biotechnol 41:684–688. https://doi.org/10.1007/BF00167285
Singleton PW, Keyser HH, Sande ES (2002) Development andevaluation of liquid inoculants. In: Herridge D (ed) Inoculants and nitrogenfixation of legumes in Vietnam ACIAR proceedings, vol 109, pp 52–66
Tittabutr P, Payakapong W, Teaumroong N, Singleton PW, Boonkerd N (2007) Growth, survival and field performance of bradyrhizobial liquid inoculant formulations with polymeric additives. Sci Asia 33:69–77
Sehgal SN, Gibbons NE (1960) Effect of metal ions on the growth of Halobacter iumcutirubrum. Can J Microbiol 5:165–169. https://doi.org/10.1139/m60-018
Zhang LH, Lang YJ, Nagata S (2009) Efficient production of ectoine using ectoine-excreting strain. Extremophiles 13:717–724. https://doi.org/10.1007/s00792-009-0262-2
Husseiny SM, Sheref FA, Amer HA, Elsakhawy TA (2015) Biosynthesis of applicable levan by a new levan producing moderately halophilic strain Chromohalobacter salexigens TA1 and its biological activities. Curr Sci Int 4(423):434
Dubois M, Gillis KA, Hamilton JK, Rebers PA, Smith F (1956) Colorimetric method for determination of sugar and related substance. Anal Chem 28:350–356. https://doi.org/10.1021/ac60111a017
Laemmli UK (1970) Cleavage of structural proteins during the assembly of the Lowry method for protein determination. Anal Biochem 155:243–248
Arndt C, Koristka S, Feldmann A, Bartsch H, Bachmann M (2012) Coomassie-brilliant blue staining of polyacrylamide gels. Protein Electrophoresis. https://doi.org/10.1007/978-1-61779-821-4_40
Bushby HVA, Marshall KC (1977) Some factors affecting the survival of root-nodule bacteria on desiccation. Soil Biol Biochem 9:143–147. https://doi.org/10.1016/0038-0717(77)90065-7
Mishustin EN, Shil’nikova VK (1968) Biological fixation of atmospheric nitrogen. Pennsylvania State University Press, London
Mugnier J, Jung G (1985) Survival of bacteria and fungi in relation to water activity and the solvent properties of water inbiopolymer gels. Appl Environ Microbiol 50:108–114
Perroud B, Lerudulier D (1985) Glycine betaine transport in Escherichia coli: osmotic modulation. J Bacteriol 161:393–401
Costerton JW (1985) The role of bacterial exopolysaccharides in nature and disease. Dev Ind Microbiol 26:249–269
Costerton JW, Irvin RT (1981) The bacterial glycocalyx in nature and disease. Annu Rev Microbiol 35:299–324
Errington JR, Pablo GD, Brian AP (2002) The stability of proteinsin a polyvinyl pyrrollidone matrix, Department of chemical engineer. Princeton University, Princeton
Zhang L, Lang Y, Wang C, Nagata S (2008) Promoting effect of compatible solute ectoine on the ethanol fermentation by Zymomonas mobilis CICC10232. Process Biochem 43:642–646. https://doi.org/10.1016/j.procbio.2008.02.003
Lorda B (1996) Designing media I and II. In: Ballatti and Freire (ed), Legume inoculants. selection and characterization of strains, production, use and management. Editorial Kingraf, Buenos Aires, p 148.
Girisha HC, Brahamprakash GP, Mallesha BC (2006) Effect of osmo protectant (PVP-40) on survival of Rhizobiumin different inoculants formulation and nitrogen fixation in cowpea. Geobios 33:151–156. https://doi.org/10.18535/ijsrm/v6i3.b02
Fetyan NA, Mansour AA (2012) Molecular, Biochemical and Physiological characterization of symbiotic bacteria isolated from saline soil in Saudi Arabia. Aust J Basic Appl Sci 6(3):229–239
Acknowledgements
This work was supported by the Agricultural Research Center, Egypt. The authors highly acknowledge the staff members of Microbiology Department, Sakha Agricultural Research Station for their support.
Funding
None.
Author information
Authors and Affiliations
Contributions
All authors contributed to experimental design, laboratory work, data analysis, drafting or revising the article, gave final approval of the version to be published, and agree to be accountable for all aspects of the work.
Corresponding author
Ethics declarations
Conflict of interest
The authors declare that they have no competing interests.
Additional information
Publisher's Note
Springer Nature remains neutral with regard to jurisdictional claims in published maps and institutional affiliations.
Rights and permissions
About this article
Cite this article
Elsakhawy, T., Ghazi, A. & Abdel-Rahman, M.A. Developing Liquid Rhizobium Inoculants with Enhanced Long-Term Survival, Storage Stability, and Plant Growth Promotion Using Ectoine Additive. Curr Microbiol 78, 282–291 (2021). https://doi.org/10.1007/s00284-020-02265-z
Received:
Accepted:
Published:
Issue Date:
DOI: https://doi.org/10.1007/s00284-020-02265-z